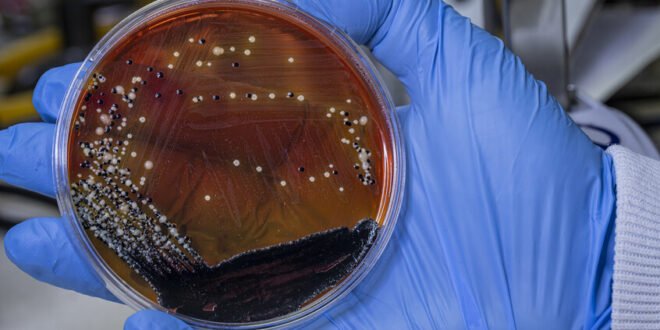

منبر العراق الحر :كشفت دراسة علمية حديثة أن بكتيريا الأمعاء البشرية الضرورية لصحة الإنسان تمتلك قدرة مذهلة على تحمل ظروف رحلات الفضاء القاسية.
وأظهرت الدراسة الأسترالية قدرة غير متوقعة لبكتيريا Bacillus subtilis على تحمل أقسى ظروف رحلات الفضاء، حيث نجحت في الصمود أمام مراحل الإطلاق والعودة عبر الغلاف الجوي للأرض، ما يضع العلماء أمام حقائق جديدة لها انعكاساتها على مستقبل الاستكشاف البشري للفضاء.
ففي تجربة فريدة قام بها باحثون أستراليون، تم إطلاق أبواغ هذه البكتيريا – التي تعيش بشكل طبيعي في الأمعاء البشرية – إلى حافة الفضاء على متن صاروخ استطلاعي بلغ ارتفاع 260 كيلومترا فوق سطح اﻷرض.
وواجهت البكتيريا خلال رحلتها ظروفا بالغة القسوة، بدءا من قوى التسارع التي بلغت 13 ضعف جاذبية الأرض أثناء الإطلاق، مرورا بحالة انعدام الوزن التي استمرت ست دقائق، ووصولا إلى قوى الكبح الهائلة التي تجاوزت 30 ضعف الجاذبية الأرضية أثناء العودة، إضافة إلى دوران بمعدل 220 دورة في الثانية.
وبعد عودة العينات إلى الأرض وفحصها، كشفت النتائج المفاجئة أن البكتيريا حافظت على هيكلها الخلوي سليما تماما دون أي تأثير يذكر على قدرتها النموية.
وتحمل هذه النتائج أهمية بالغة لصحة رواد الفضاء في البعثات طويلة الأمد مثل الرحلات إلى المريخ، حيث يعتمد التوازن الصحي للجسم بشكل كبير على استقرار البيئة البكتيرية في الأمعاء.
من ناحية أخرى، تثير هذه النتائج تحذيرات علمية جدية حول إمكانية تلويث الكواكب الأخرى بالبكتيريا الأرضية، خاصة مع استعداد وكالات الفضاء حول العالم لإرسال بعثات مأهولة إلى المريخ.
وقد حذرت دراسة سابقة من أن بعض البكتيريا الأرضية يمكن أن تجد في التربة المريخية بيئة مناسبة للعيش، ما يهدد بإرباك عمليات البحث عن حياة مريخية أصلية، ويشكل خطرا محتملا على صحة رواد الفضاء أنفسهم.
وتظهر هذه الدراسة الحاجة الماسة لتطوير بروتوكولات أكثر صرامة لحماية النظم البيئية للكواكب الأخرى، مع الحفاظ في الوقت نفسه على صحة رواد الفضاء وضمان نجاح المهام الاستكشافية المستقبلية.
المصدر: gizmodo
 منبر العراق الحر منبر العراق الحر
منبر العراق الحر منبر العراق الحر